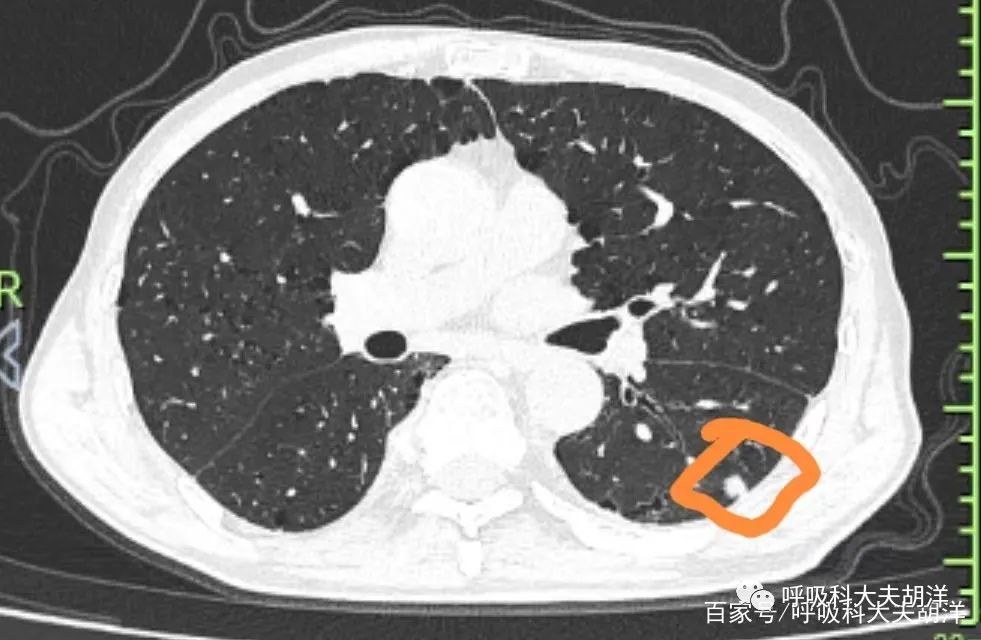

- +1
看不懂结节的良恶性,就看看这个RADS分级,分级越高越是偏向恶性
原创 胡洋大夫 呼吸科大夫胡洋
一个网友在网上咨询:最近体检做了胸部CT,报告写着7mm实性肺结节,RADS 3级,不知道这个3级代表什么意思?会不会是恶性呢?
相信有很多查出来结节的患者都想知道自己的结节到底是不是恶性,但有时候找医生很难,要去医院排队,挂号,想想医院人山人海的场景就望而却步,上网找科普来对照有觉得不靠谱,科普文章良莠不齐,就算搜到靠谱的科普,很多读也读不懂,看也看不明白,看得明白有隔行如隔山,照着文章里讲的去套又感觉套不出什么所以然来,这时候怎么办呢?可以看一下CT报告上的RADS分级。
肺结节RADS分级是肺结节分类的一种方式,通常是依据CT下结节的大小、密度、形态学状况、生长速度等,将肺结节分为6个等级。其目的是辅助评估肺结节的良、恶性,或者说判断高危还是低危结节。
1类(阴性,恶性概率<1%)
无肺结节或确定为良性的肺结节(含良性钙化或脂肪)。这类结节属于低危结节,只需要12个月年度低剂量胸部CT随访就可以了。
2类(良性结节,恶性概率<1%)
多为良性结节,发展为临床侵袭性肺癌的可能性很低,通常包括8种情况,即良性钙化结节、叶间裂结节、含脂质的错构瘤、球形肺不张、活检为良性的结节、5mm内的结节、直径≥5毫米的亚实性密度结节随访稳定5年以上或者≥5毫米的实性密度结节随访稳定2年以上,也为2类肺结节,这类肺结节同样为12个月年度定期复查即可。
3类(未定性结节 恶性概率1-2%)
对于新发或初筛的结节直径大于10毫米,进行CT检查时可能出现模糊或磨玻璃边缘、部分磨玻璃密度、树芽征、卫星灶等特征都归为三类结节。随访2年内稳定的实性结节或者随访时间小于5年内的稳定的亚实性结节,如果结节直径在5-9毫米之间,也归为3类肺结节。处理:一般建议6个月随访复查。
 4类(可疑恶性结节)
4类(可疑恶性结节)4类结节又细分为4a、4b、4c三类。4a类结节为10-25mm实性结节伴不明确的良性征象。恶性概率为5~15%。处理为:3个月低剂量胸部 CT 筛查;存在≥8mm的实性成分时需 P ET / CT 检查。
4b类结节为持续存在的直径≥10毫米的亚实性密度结节,实性成分≤5毫米。恶性概率>15%。为原位癌或微小浸润癌可能。处理:胸部 CT 增强或平扫靶扫描;根据恶性的概率和并发症,选择性进行PET / CT 和/或组织活检;存在≥8mm的实性成分时,需进行 PET / CT 检查。
4c的恶性率较高,通常为部分实性结节(实性成分≥5mm)在短期随访中无明显改善。直径≥10mm的结节,边界清晰、有分叶及毛刺、无炎症性病变也定义为4C类肺结节。处理方式与4b类相同。
5类
5类5类肺结节是指进行CT检查时,强烈提示为恶性结节。建议尽早进行病理检查或者手术,选择性进行PET-CT。
6类
6类肺结节是指进行细针抽吸细胞学检查、中心活检等组织学检查,已明确为恶性结节。建议尽早手术,可以选择性进行PET-CT检查。
结节分类其实是动态的,比如初筛时为2类的结节,如果随访中增大,实性成分增多,就有可能后面划入4类,所以对于肺结节良恶性的判断,更重要的还是随访,前后对比。此外,还应通过是否有肺癌家族史、是否有长期吸烟、职业暴露等肺癌的高危因素等情况综合判断。
原标题:《看不懂结节的良恶性,就看看这个RADS分级,分级越高越是偏向恶性》
本文为澎湃号作者或机构在澎湃新闻上传并发布,仅代表该作者或机构观点,不代表澎湃新闻的观点或立场,澎湃新闻仅提供信息发布平台。申请澎湃号请用电脑访问http://renzheng.thepaper.cn。





- 报料热线: 021-962866
- 报料邮箱: news@thepaper.cn
互联网新闻信息服务许可证:31120170006
增值电信业务经营许可证:沪B2-2017116
© 2014-2026 上海东方报业有限公司




